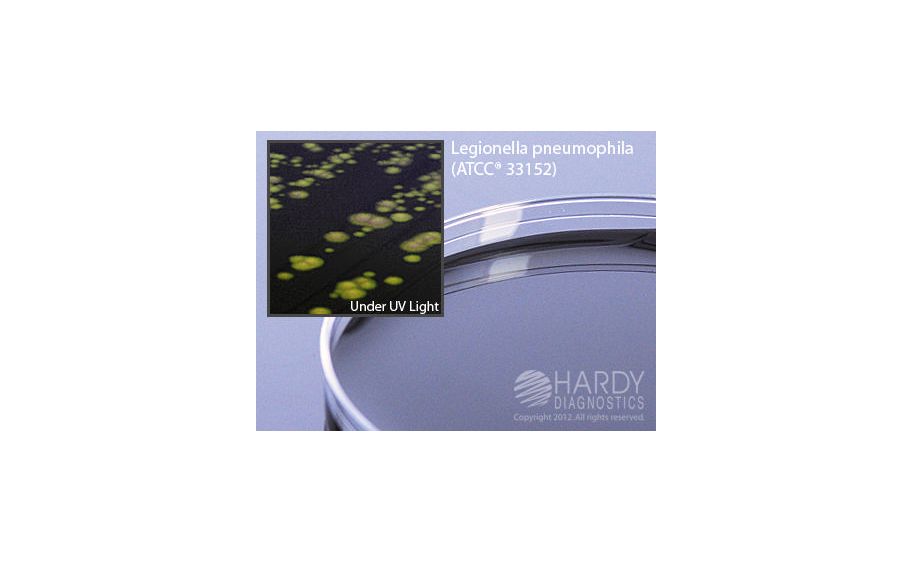
main product photo

Need Help?
800-229-7252

BCYE AGAR 15X100MM PLATE F/LEGIONELLA SP
1
/
PK
Lead Time
12 Day(s)
SKU
VWR75820-342-PK
MFRPN
G07
BCYE AGAR 15X100MM PLATE F/LEGIONELLA SP
BCYE AGAR 15X100MM PLATE F/LEGIONELLA SP
| Manufacturer | Hardy Diagnostics |
|---|---|
| MFRPN | G07 |
| Lead Time | 12 Day(s) |
| UNSPSC Code | 12000000 |
Write Your Own Review